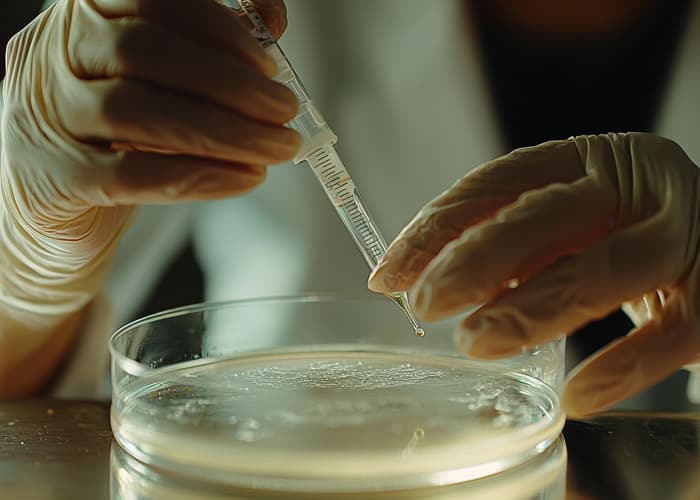
Skincare Fermentation

K-Beauty Secrets are evolving, and at the center of this evolution is fermented botanical skincare — a clinically supported upgrade to traditional plant extracts. Many people struggle with dullness, barrier weakness, and formulas that stop working over time. These issues often trace back to poor absorption and low bioactive delivery.
Fermentation solves this problem by breaking botanicals into smaller, skin-compatible compounds that penetrate deeper and act faster. This is why dermatologists and innovators in Korean skincare now rely on precise fermentation technology.
Refine your skincare routine and elevate results.
The Basics of Skincare Fermentation
Fermentation is a controlled biochemical reaction where beneficial microorganisms convert raw plant materials into smaller, more potent molecules. Historically used in Korean herbal medicine, the same process now shapes modern clean skincare and natural skin care formulations. Dermatologists appreciate it because it increases potency without destabilizing the ingredients.
During fermentation, enzymes break down complex compounds into amino acids, peptides, and organic acids. This enhances penetration and reduces irritation, making the final ingredient more compatible with everyday skincare routine use. K-beauty labs optimize temperature, microbial strain, and timing to achieve consistent, high-performance extracts.
Fermentation x Probiotics: The Microbial Magic Behind Skincare
Probiotics work like tiny chemists, transforming raw botanicals into bioactive compounds known as postbiotics. These postbiotics strengthen the skin barrier, regulate microbiome balance, and calm inflammation. This is why probiotic skincare products are central to microbiome-focused K-beauty research.
Fermentation improves stability, increases nutrient density, and enhances antioxidant potential. Molecules become smaller, allowing deeper penetration and better clinical outcomes which is key to high performing Botanical Skincare.
Comparing Fermented vs. Non-Fermented Skincare

Fermented formulas consistently outperform non-fermented counterparts, which explains the exponential rise of K-Beauty Fermented Products globally.
Here is your clinical comparison table:
Feature | Non-Fermented Botanicals | Fermented Botanicals |
| Molecular Size | Larger, harder to absorb | Smaller, highly absorbable |
| Irritation Risk | Moderate | Lower due to breakdown of irritants |
| Antioxidant Activity | Baseline | Up to 2–3× higher |
| Texture | Raw, sometimes sticky | Silky, refined |
| Stability | Variable | More stable & bioactive |
| Effectiveness | Moderate | Higher due to increased bioavailability |
Benefits of Using Fermented Ingredients in Korean Skincare

Fermented botanicals work well for anti-aging skin care, helping reduce dullness, fine lines, and uneven texture. Korean dermatologists often recommend fermented actives for patients seeking gentle but high-yield results.
Better Bioavailability
Bioavailability determines how effectively the skin uses every drop of a product. Fermentation maximizes this by making active molecules smaller, faster, and more targeted. This ensures your fermented skincare routine works harder without increasing concentration.
“Micro-sized molecules = macro-level results.”
Top Fermented Botanicals Loved by Formulators

K-beauty formulators frequently use fermented ginseng, green tea, lotus, rice water, and Centella. These ingredients show enhanced antioxidant behavior and better soothing capacity, making them staples of K-Beauty Skincare, Natural Korean Skincare, and Fermented Ingredients Skincare innovation pipelines.
Future Trends & Biotech Innovation
The future of fermentation includes AI-guided microbial engineering, precision postbiotic blends, and encapsulated fermented actives for controlled release. These advancements will elevate Korean fermented skincare benefits beyond traditional botanicals. Fermented skincare merges tradition with advanced dermatological science. It improves potency, enhances absorption, and delivers measurable results with gentleness. If you want a clinically strong yet aesthetic K-beauty glow, fermented skincare is the category to watch.
“Fermentation is the quiet technology redefining modern beauty.”





